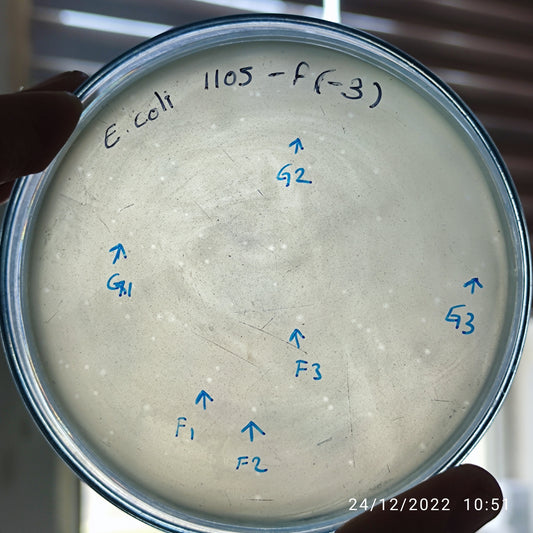
Escherichia coli bacteriophage 101105G
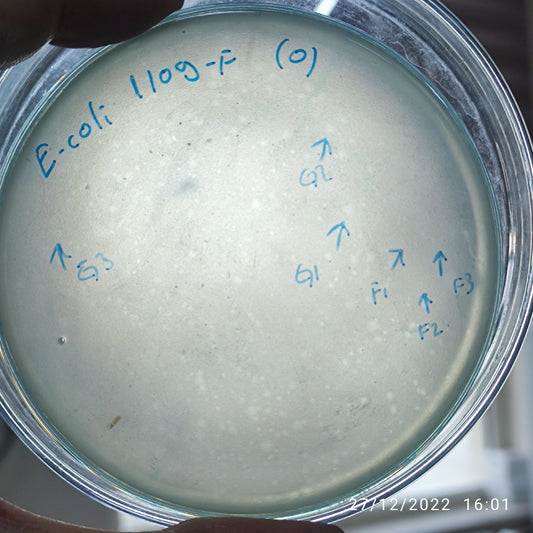
Escherichia coli bacteriophage 101109G
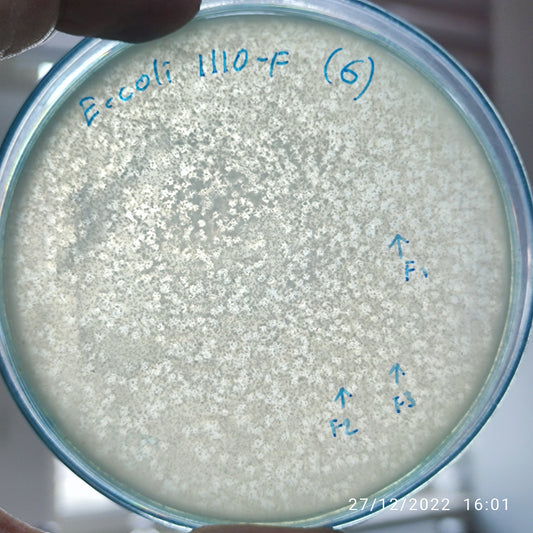
Escherichia coli bacteriophage 101110F
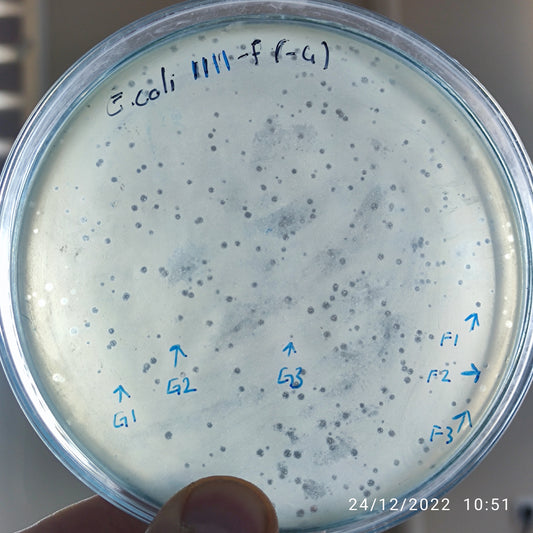
Escherichia coli bacteriophage 101111G
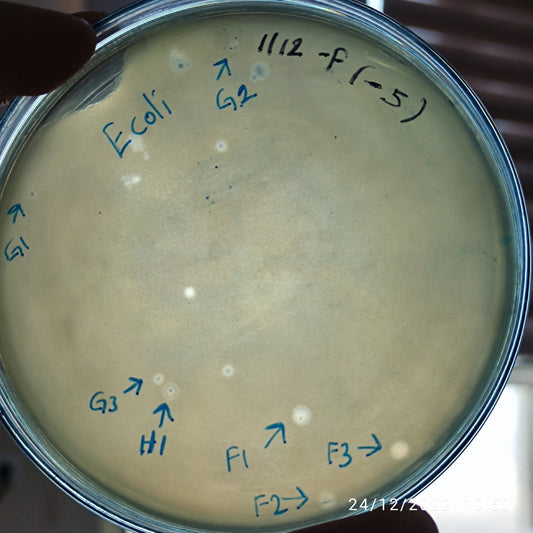
Escherichia coli bacteriophage 101112F
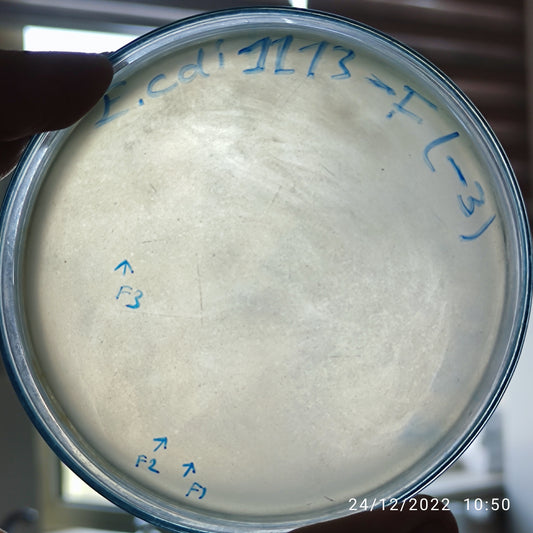
Escherichia coli bacteriophage 101113F
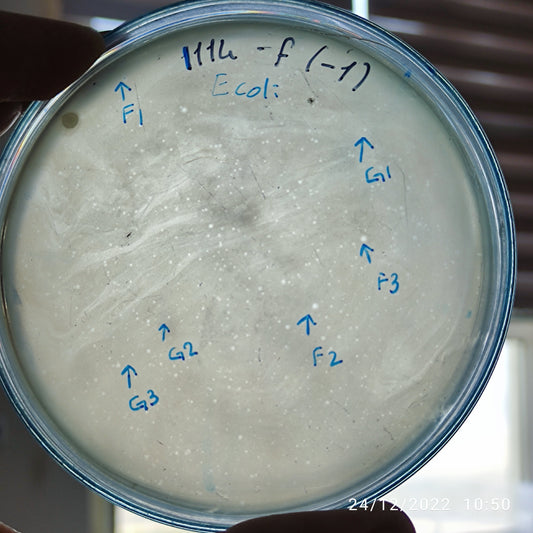
Escherichia coli bacteriophage 101114F
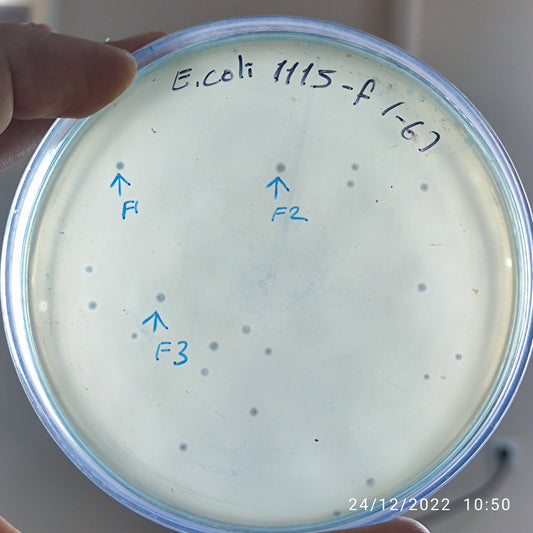
Escherichia coli bacteriophage 101115F
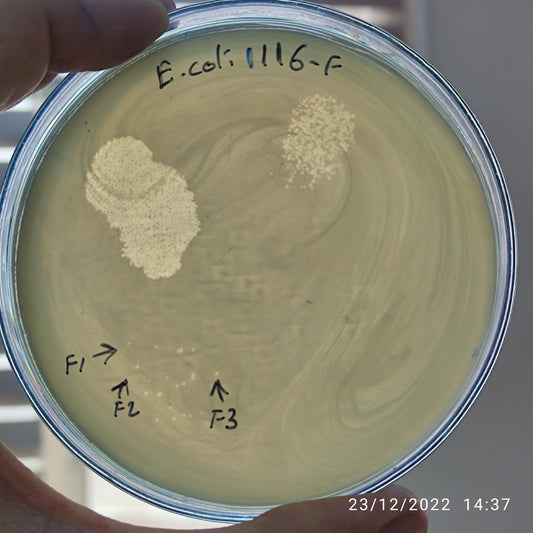
Escherichia coli bacteriophage 101116F
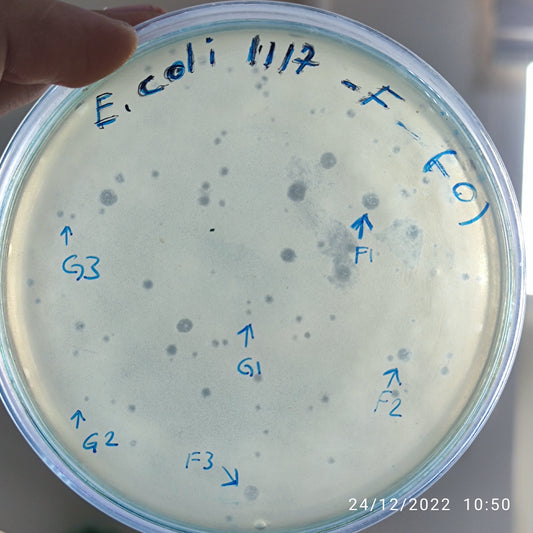
Escherichia coli bacteriophage 101117F

-
Escherichia coli bacteriophage 101105F
Regular price $500.00 USDRegular priceUnit price per -
Escherichia coli bacteriophage 101105G
Regular price $500.00 USDRegular priceUnit price per -
Escherichia coli bacteriophage 101109F
Regular price $500.00 USDRegular priceUnit price per -
Escherichia coli bacteriophage 101109G
Regular price $500.00 USDRegular priceUnit price per -
Escherichia coli bacteriophage 101110F
Regular price $500.00 USDRegular priceUnit price per -
Escherichia coli bacteriophage 101111F
Regular price $500.00 USDRegular priceUnit price per -
Escherichia coli bacteriophage 101111G
Regular price $500.00 USDRegular priceUnit price per -
Escherichia coli bacteriophage 101112F
Regular price $500.00 USDRegular priceUnit price per -
Escherichia coli bacteriophage 101112G
Regular price $500.00 USDRegular priceUnit price per -
Escherichia coli bacteriophage 101113F
Regular price $400.00 USDRegular priceUnit price per -
Escherichia coli bacteriophage 101114F
Regular price $500.00 USDRegular priceUnit price per -
Escherichia coli bacteriophage 101114G
Regular price $500.00 USDRegular priceUnit price per -
Escherichia coli bacteriophage 101115F
Regular price $500.00 USDRegular priceUnit price per -
Escherichia coli bacteriophage 101116F
Regular price $500.00 USDRegular priceUnit price per -
Escherichia coli bacteriophage 101117F
Regular price $500.00 USDRegular priceUnit price per -
Escherichia coli bacteriophage 101117G
Regular price $500.00 USDRegular priceUnit price per